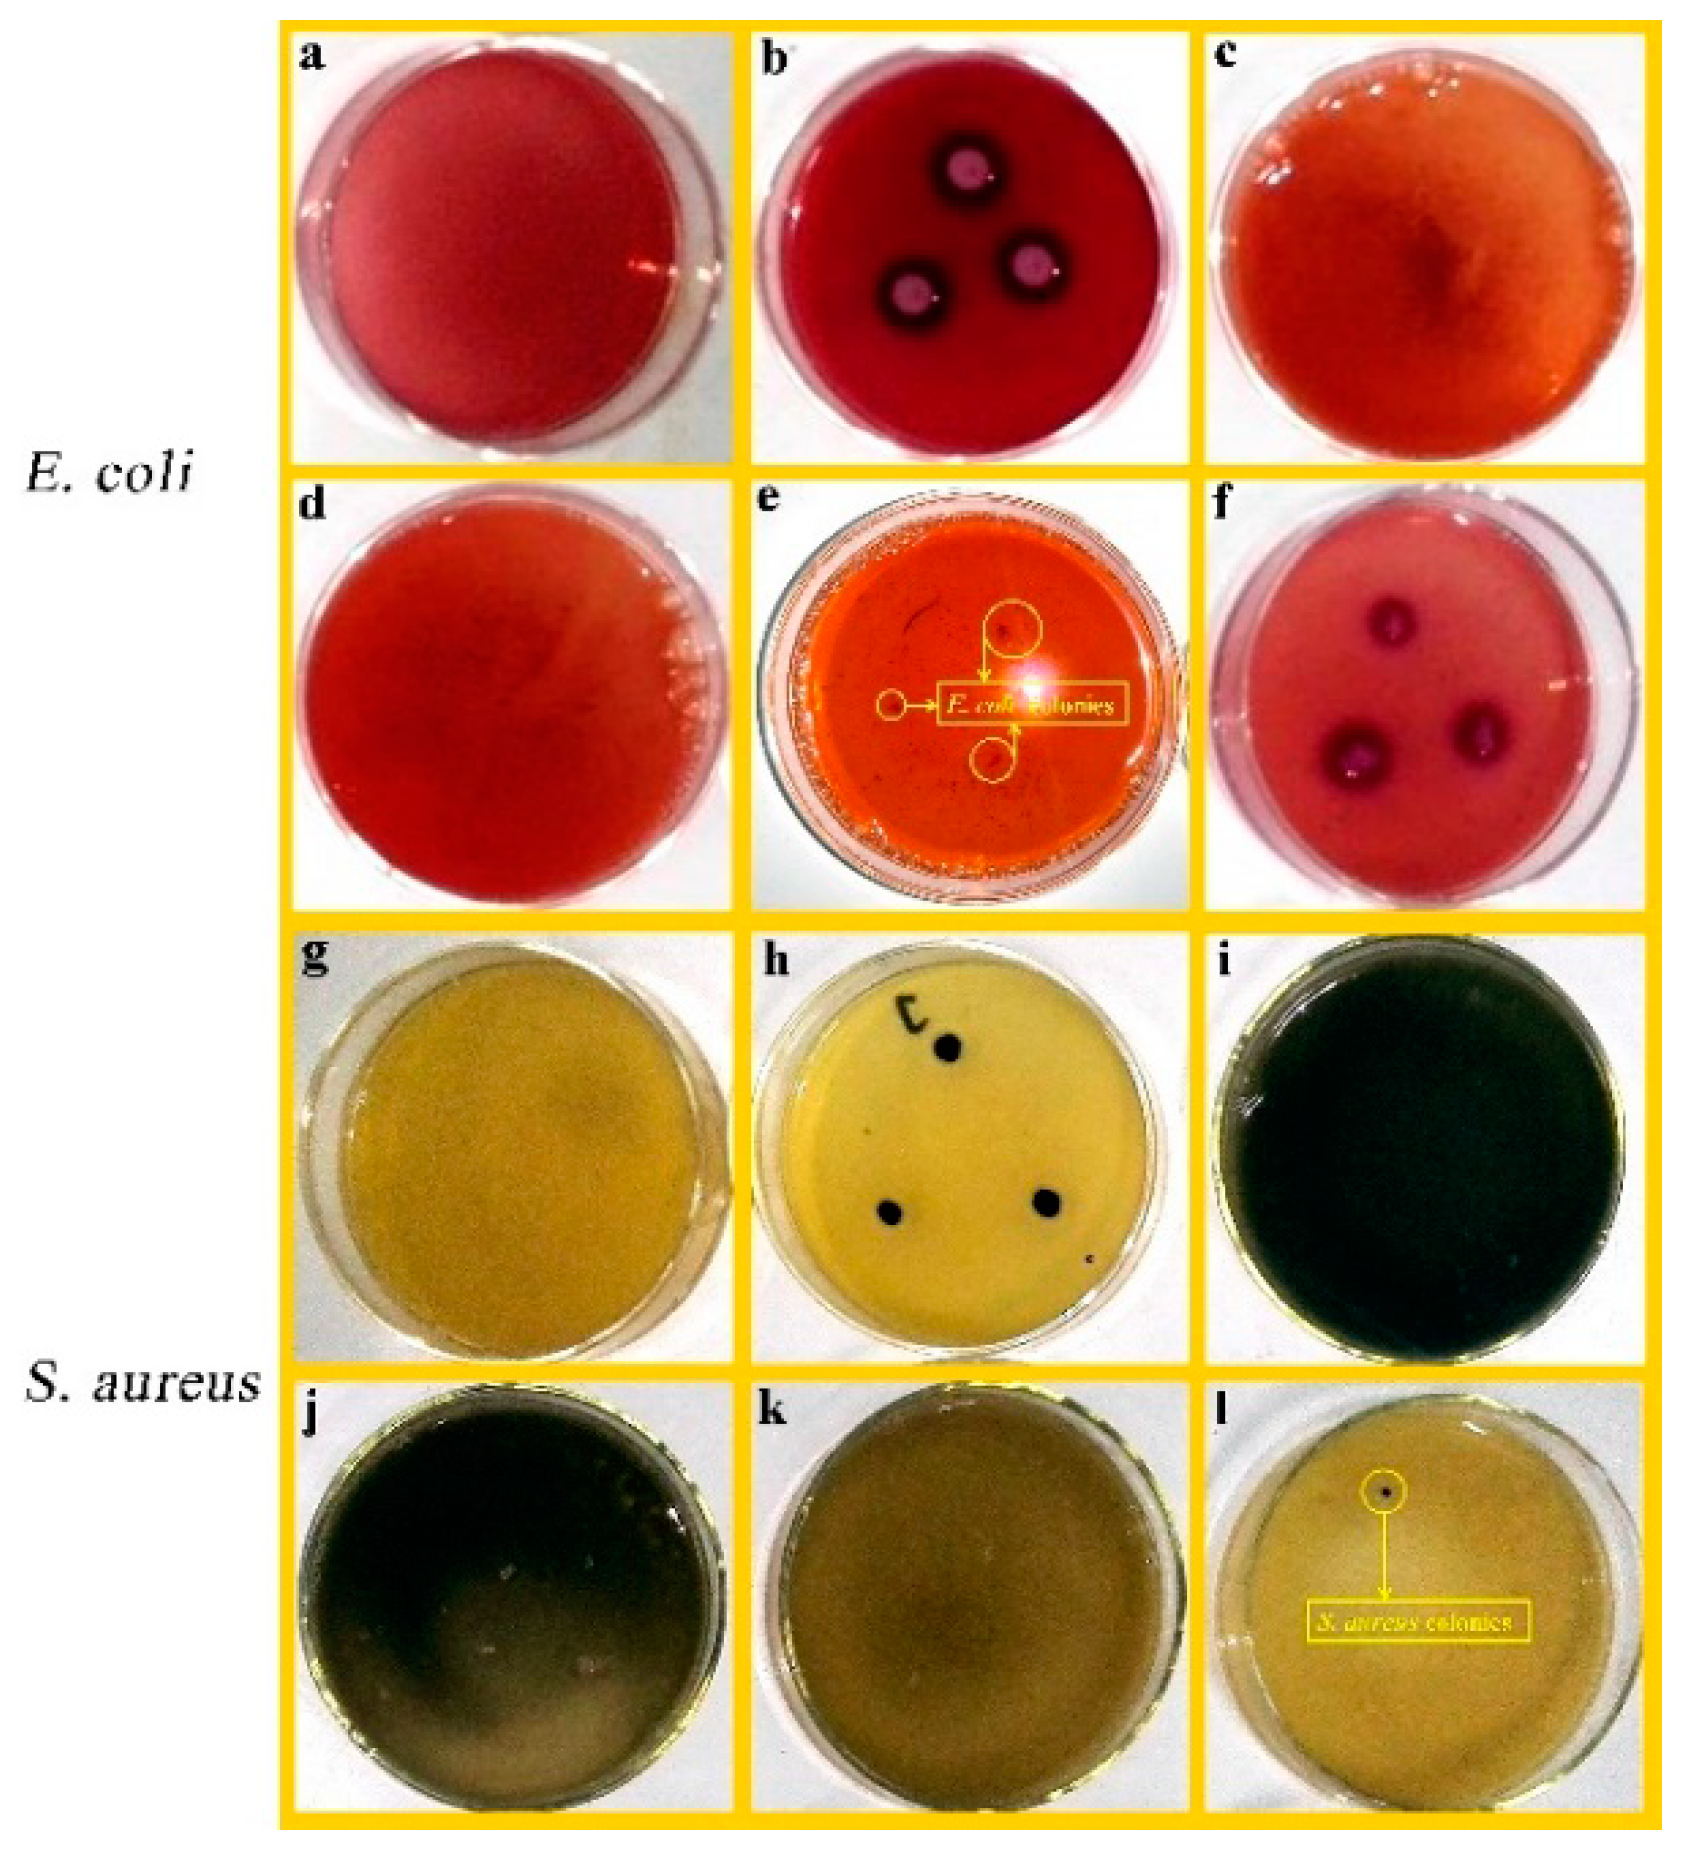
Nanomaterials 11 03230 g007
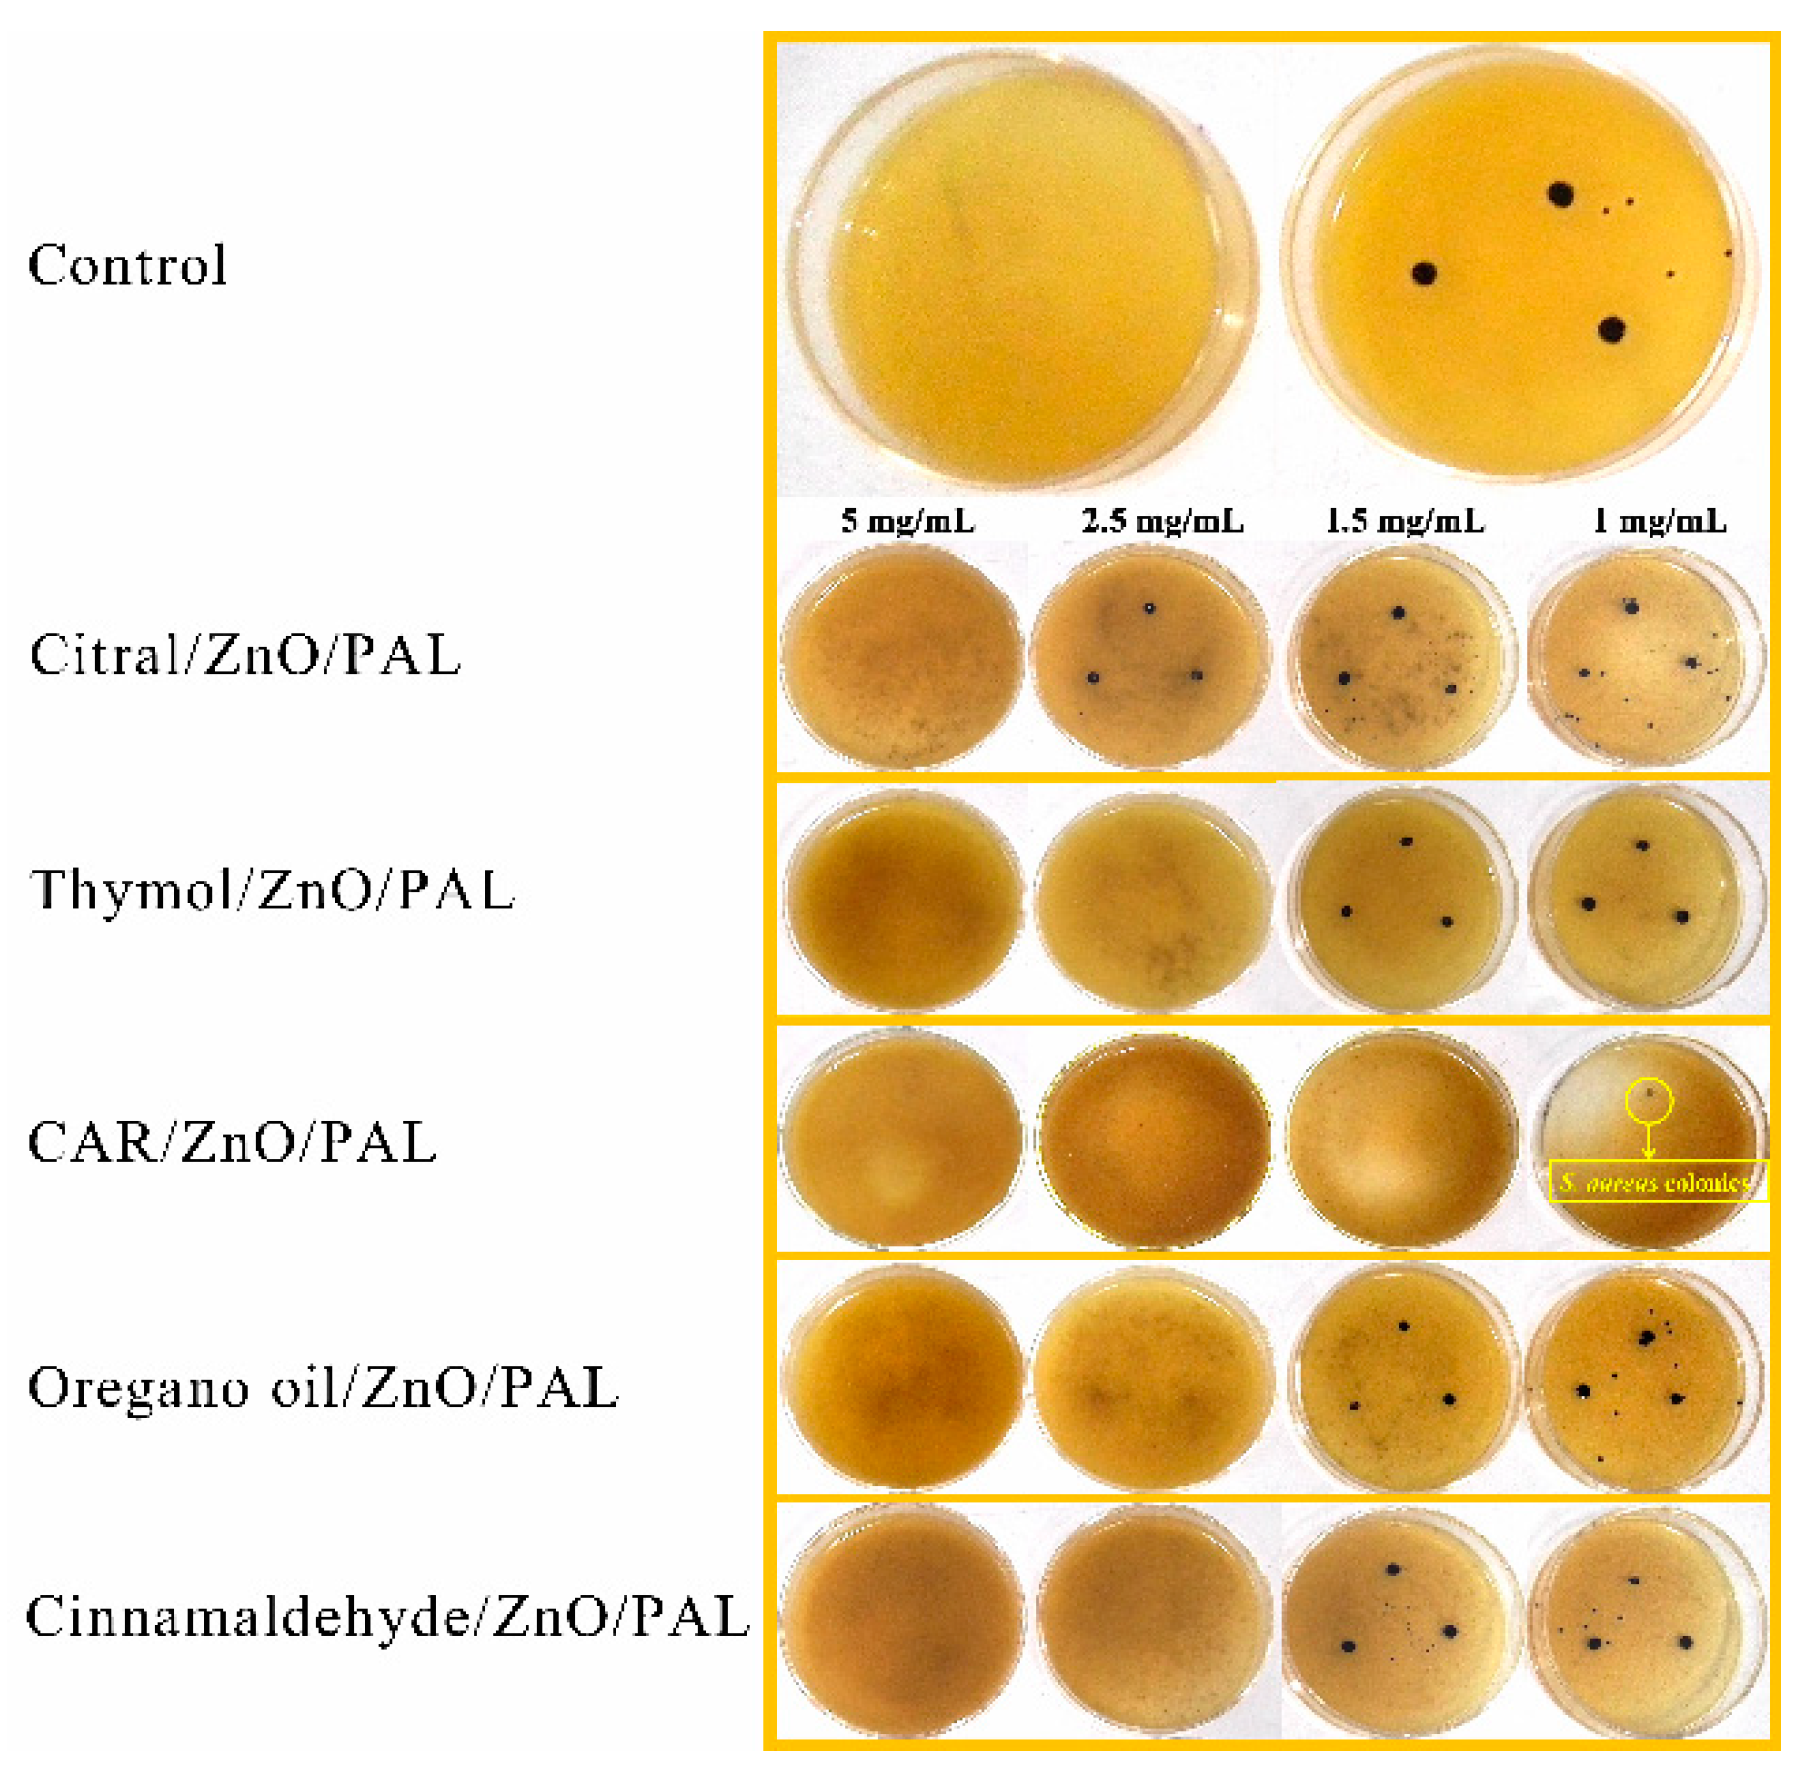
Nanomaterials 11 03230 g009

Palygorskite-Based Organic–Inorganic Hybrid Nanocomposite for Enhanced Antibacterial Activities
Abstract
:1. Introduction
2. Materials and Methods
2.1. Materials
2.2. Preparation of PEOs/ZnO/PAL
2.3. Characterization
2.4. Antibacterial Assay
3. Results and Discussion
3.1. Possible Formation Mechanism of PEOs/ZnO/PAL
3.2. FTIR
3.3. XRD Patterns
3.4. TG Curves
3.5. SEM and TEM
3.6. BET Analysis
3.7. Antibacterial Evaluation
4. Conclusions
Supplementary Materials
Author Contributions
Funding
Institutional Review Board Statement
Informed Consent Statement
Conflicts of Interest
References
- Gyawali, R.; Ibrahim, S.A. Natural products as antimicrobial agents. Food Control 2014, 46, 412–429. [Google Scholar] [CrossRef]
- Hu, W.; Li, C.Z.; Dai, J.M.; Cui, H.Y.; Lin, L. Antibacterial activity and mechanism of Litsea cubeba essential oil against methicillin-resistant Staphylococcus aureus (MRSA). Ind. Crop. Prod. 2019, 130, 34–41. [Google Scholar] [CrossRef]
- Jayasena, D.D.; Jo, C. Essential oils as potential antimicrobial agents in meat and meat products: A review. Trends Food Sci. Tech. 2013, 34, 96–108. [Google Scholar] [CrossRef]
- Moon, S.H.; Waite-Cusic, J.; Huang, E. Control of Salmonella in chicken meat using a combination of a commercial bacteriophage and plant-based essential oils. Food Control 2020, 110, 106984. [Google Scholar] [CrossRef]
- Ni, Z.J.; Wang, X.; Shen, Y.; Thakur, K.; Han, J.Z.; Zhang, J.G.; Hu, F.; Wei, Z.J. Recent updates on the chemistry, bioactivities, mode of action, and industrial applications of plant essential oils. Trends Food Sci. Tech. 2021, 110, 78–89. [Google Scholar] [CrossRef]
- Calo, J.R.; Crandall, P.G.; O’Bryan, C.A.; Ricke, S.C. Essential oils as antimicrobials in food systems: A review. Food Control 2015, 54, 111–119. [Google Scholar] [CrossRef]
- He, F.; Wang, W.; Wu, M.C.; Fang, Y.P.; Wang, S.Z.; Yang, Y.; Ye, C.; Xiang, F. Antioxidant and antibacterial activities of essential oil from Atractylodes lancea rhizomes. Ind. Crop. Prod. 2020, 153, 112552. [Google Scholar] [CrossRef]
- Karpiński, T.M. Essential oils of lamiaceae family plants as antifungals. Biomolecules 2020, 10, 103. [Google Scholar] [CrossRef] [Green Version]
- Erasto, P.; Bojase-Moleta, G.; Majinda, R.R.T. Antimicrobial and antioxidant flavonoids from the root wood of Bolusanthus speciosus. Phytochemistry 2004, 65, 875–880. [Google Scholar] [CrossRef]
- Rahman, M.M.; Gray, A.I. Antimicrobial constituents from the stem bark of Feronia limonia. Phytochemistry 2002, 59, 73–77. [Google Scholar] [CrossRef]
- Reyes-Jurado, F.; Navarro-Cruz, A.R.; Ochoa-Velasco, C.E.; Palou, E.; López-Malo, A.; Ávila-Sosa, R. Essential oils in vapor phase as alternative antimicrobials: A review. Crit. Rev. Food Sci. 2019, 60, 1641–1650. [Google Scholar] [CrossRef]
- Wang, F.W.; You, H.Q.; Guo, Y.H.; Wei, Y.K.; Xia, P.G.; Yang, Z.Q.; Ren, M.; Guo, H.; Han, R.L.; Yang, D.F. Essential oils from three kinds of fingered citrons and their antibacterial activities. Ind. Crop. Prod. 2020, 147, 112172. [Google Scholar] [CrossRef]
- Zhu, X.F.; Zhang, H.X.; Lo, R. Phenolic compounds from the leaf extract of artichoke (leaf extract of artichoke (Cynara scolymus L.) and their antimicrobial activities. J. Agric. Food Chem. 2004, 52, 7272–7278. [Google Scholar] [CrossRef]
- Bajpai, V.K.; Baek, K.H.; Kang, S.C. Control of Salmonella in foods by using essential oils: A review. Food Res. Int. 2012, 45, 722–734. [Google Scholar] [CrossRef]
- Cui, H.Y.; Zhang, C.H.; Li, C.Z.; Lin, L. Antibacterial mechanism of oregano essential oil. Ind. Crop. Prod. 2019, 139, 111498. [Google Scholar] [CrossRef]
- Marchese, A.; Orhan, I.E.; Daglia, M.; Barbieri, R.; Di, L.A.; Nabavi, S.F.; Gortzi, O.; Izadi, M.; Nabavi, S.M. Antibacterial and antifungal activities of thymol: A brief review of the literature. Food Chem. 2016, 210, 402–414. [Google Scholar] [CrossRef]
- Chorianopoulos, N.; Kalpoutzakis, E.; Aligiannis, N.; Mitaku, S.; Nychas, G.J.; Haroutounian, S.A. Essential oils of Satureja, Origanum, and Thymus species: Chemical composition and antibacterial activities against foodborne pathogens. J. Agric. Food Chem. 2004, 52, 8261–8267. [Google Scholar] [CrossRef] [PubMed]
- Maggio, A.; Rosselli, S.; Bruno, M. Essential oils and pure volatile compounds as potential drugs in Alzheimer’s disease therapy: An updated review of the literature. Curr. Pharm. Des. 2016, 22, 4011–4027. [Google Scholar] [CrossRef]
- Akbari-Alavijeh, S.; Shaddel, R.; Jafari, S.M. Encapsulation of food bioactives and nutraceuticals by various chitosan-based nanocarriers. Food Hydrocoll. 2020, 105, 105774. [Google Scholar] [CrossRef]
- Moghimi, R.; Ghaderi, L.; Rafati, H.; Aliahmadi, A.; McClements, D.J. Superior antibacterial activity of nanoemulsion of Thymus daenensis essential oil against E. coli. Food Chem. 2016, 194, 410–415. [Google Scholar] [CrossRef]
- Hui, A.P.; Liu, J.L.; Ma, J.Z. Synthesis and morphology-dependent antimicrobial activity of cerium doped flower-shaped ZnO crystallites under visible light irradiation. Coll. Surf. A 2016, 506, 519–525. [Google Scholar] [CrossRef]
- Liu, J.L.; Shao, J.Z.; Wang, Y.h.; Li, J.Q.; Liu, H.; Wang, A.Q.; Hui, A.P.; Chen, S.W. Antimicrobial activity of zinc oxide-graphene quantum dot nanocomposites: Enhanced adsorption on bacterial cells by cationic capping polymers. ACS Sustain. Chem. Eng. 2019, 7, 16264–16273. [Google Scholar] [CrossRef]
- Raghunath, A.; Perumal, E. Metal oxide nanoparticles as antimicrobial agents: A promise for the future. Int. J. Antimicrob. Agents 2017, 49, 137–152. [Google Scholar] [CrossRef] [PubMed]
- Yan, Y.; Kuang, W.; Shi, L.; Ye, X.; Yang, Y.; Xie, X.; Tan, S. Carbon quantum dot-decorated TiO2 for fast and sustainable antibacterial properties under visible-light. J. Alloys Compd. 2019, 777, 234–243. [Google Scholar] [CrossRef]
- Zhu, X.W.; Wu, D.; Wang, W.; Tan, F.T.; Wong, P.K.; Wang, X.Y.; Qiu, X.L.; Qiao, X.L. Highly effective antibacterial activity and synergistic effect of Ag-MgO nanocomposite against Escherichia coli. J. Alloys Compd. 2016, 684, 282–290. [Google Scholar] [CrossRef]
- Bilia, A.R.; Guccione, C.; Isacchi, B.; Righeschi, C.; Firenzuoli, F.; Bergonzi, M.C. Essential oils loaded in nanosystems: A developing strategy a successful therapeutic approach. Evid-Based Complement Altern. Med. 2014, 2014, 651593. [Google Scholar] [CrossRef] [Green Version]
- Brayner, R.; Ferrari-Iliou, R.; Brivois, N.; Djediat, S.; Benedetti, M.F.; Fievet, F. Toxicological impact studies based on Escherichia coli bacteria in ultrafine ZnO nanoparticles colloidal medium. Nano Lett. 2006, 6, 866–870. [Google Scholar] [CrossRef]
- Jiang, Y.; Zhang, L.; Wen, D.; Ding, Y. Role of physical and chemical interactions in the antibacterial behavior of ZnO nanoparticles against E. coli. Mater. Sci. Eng. C 2016, 69, 1361–1366. [Google Scholar] [CrossRef]
- Applerot, G.; Lipovsky, A.; Dror, R.; Perkas, N.; Nitzan, Y.; Lubart, R.; Gedanken, A. Enhanced antibacterial activity of nanocrystalline ZnO due to increased ROS-mediated cell injury. Adv. Funct. Mater. 2009, 19, 842–852. [Google Scholar] [CrossRef]
- Alswat, A.A.; Ahmad, M.B.; Saleh, T.A.; Hussein, M.Z.B.; Ibrahim, N.A. Effect of zinc oxide amounts on the properties and antibacterial activities of zeolite/zinc oxide nanocomposite. Mater. Sci. Eng. C 2016, 68, 505–511. [Google Scholar] [CrossRef]
- Hui, A.P.; Dong, S.Q.; Kang, Y.R.; Zhou, Y.M.; Wang, A.Q. Hydrothermal fabrication of spindle-shaped ZnO/palygorskite nanocomposites using nonionic surfactant for enhancement of antibacterial activity. Nanomaterials 2019, 9, 1453. [Google Scholar] [CrossRef] [Green Version]
- Huo, C.L.; Yang, H.M. Synthesis and characterization of ZnO/palygorskite. Appl. Clay Sci. 2010, 50, 362–366. [Google Scholar] [CrossRef]
- Leone, F.; Cataldo, R.; Mohamed, S.S.Y.; Manna, L.; Banchero, M.; Ronchetti, S.; Mandras, N.; Tullio, V.; Cavalli, R.; Onida, B. Nanostructured ZnO as multifunctional carrier for a green antibacterial drug delivery system-a feasibility study. Nanomaterials 2019, 9, 407. [Google Scholar] [CrossRef] [PubMed] [Green Version]
- Dong, W.K.; Lu, Y.S.; Wang, W.B.; Zhang, M.M.; Jing, Y.M.; Wang, A.Q. A sustainable approach to fabricate new 1D and 2D nanomaterials from natural abundant palygorskite clay for antibacterial and adsorption. Chem. Eng. J. 2020, 382, 122984. [Google Scholar] [CrossRef]
- Tang, J.; Mu, B.; Zong, L.; Wang, A.Q. One-step synthesis of magnetic attapulgite/carbon supported NiFe-LDHs by hydrothermal process of spent bleaching earth for pollutants removal. J. Clean. Prod. 2018, 172, 673–685. [Google Scholar] [CrossRef]
- Zhang, R.Q.; Zhou, Y.M.; Jiang, X.Y.; Chen, Y.P.; Wen, C.; Liu, W.B.; Jiang, Y. Evaluation Of zinc-bearing palygorskite effects on growth performance, nutrient retention, meat quality, and zinc accumulation in blunt snout bream Megalobrama Amblycephala. Clays Clay Miner. 2018, 66, 274–285. [Google Scholar] [CrossRef]
- Rosendo, F.R.; Pinto, L.I.; de Lima, I.S.; Trigueiro, P.; Honório, L.M.D.C.; Fonseca, M.G.; Osajima, J.A. Antimicrobial efficacy of building material based on ZnO/palygorskite against Gram-negative and Gram-positive bacteria. Appl. Clay Sci. 2020, 188, 105499. [Google Scholar] [CrossRef]
- Hui, A.P.; Yan, R.; Wang, W.B.; Wang, Q.; Zhou, Y.M.; Wang, A.Q. Incorporation of quaternary ammonium chitooligosaccharides on ZnO/palygorskite nanocomposites for enhancing antibacterial activities. Carbohydr. Polym. 2020, 247, 116685. [Google Scholar] [CrossRef]
- Zhang, Y.; Wang, W.B.; Mu, B.; Wang, Q.; Wang, A.Q. Effect of grinding time on fabricating a stable methylene blue/palygorskite hybrid nanocomposite. Powder Technol. 2015, 280, 173–179. [Google Scholar] [CrossRef]
- Wang, X.W.; Mu, B.; Hui, A.P.; Wang, Q.; Wang, A.Q. Low-cost bismuth yellow hybrid pigments derived from attapulgite. Dye. Pigment. 2018, 149, 521–530. [Google Scholar] [CrossRef]
- Mu, B.; Kang, Y.R.; Wang, A.Q. Preparation of a polyelectrolyte-coated magnetic attapulgite composite for the adsorption of precious metals. J. Mater. Chem. A 2013, 1, 4804–4811. [Google Scholar] [CrossRef]
- Mcnab, A.I.; Mccue, A.J.; Dionisi, D.; Anderson, J.A. Quantification and qualification by in-situ FTIR of species formed on supported-cobalt catalysts during the Fischer-Tropsch reaction. J. Catal. 2017, 353, 286–294. [Google Scholar] [CrossRef]
- Zhong, H.Q.; Mu, B.; Yan, P.J.; Jing, Y.M.; Hui, A.P.; Wang, A.Q. A comparative study on surface/interface mechanism and antibacterial properties of different hybrid materials prepared with essential oils active ingredients and palygorskite. Coll. Surf. A 2021, 618, 126455. [Google Scholar] [CrossRef]
- Xu, J.X.; Wang, W.B.; Wang, A.Q. Stable formamide/palygorskite nanostructure hybrid material fortified by high-pressure homogenization. Powder Technol. 2017, 318, 1–7. [Google Scholar] [CrossRef]
- Zhong, H.Q.; Mu, B.; Zhang, M.M.; Hui, A.P.; Kang, Y.R.; Wang, A.Q. Preparation of effective carvacrol/attapulgite hybrid antibacterial materials by mechanical milling. J. Porous Mater. 2020, 27, 843–853. [Google Scholar] [CrossRef]
- Mao, C.Y.; Xiang, Y.M.; Liu, X.M.; Cui, Z.D.; Yang, X.J.; Wai, K.; Yeung, K.; Pan, H.B.; Wang, X.B.; Chu, P.K.; et al. Photo-inspired antibacterial activity and wound healing acceleration by hydrogel embedded with Ag/Ag@AgCl/ZnO nanostructures. ACS Nano 2017, 11, 9010–9021. [Google Scholar] [CrossRef]
- Kiskó, G.; Roller, S. Carvacrol and p-cymene inactivate Escherichia coli O157: H7 in apple juice. BMC Microbiol. 2005, 5, 36. [Google Scholar] [CrossRef] [Green Version]
- Peretto, G.; Du, W.X.; Avenabustillos, R.J.; Berrios, J.D.J.; Sambo, P.; Mchugh, T.H. Optimization of antimicrobial and physical properties of alginate coatings containing carvacrol and methyl cinnamate for strawberry application. J. Agric. Food Chem. 2014, 62, 984–990. [Google Scholar] [CrossRef] [PubMed]
- Liu, J.L.; Rojas-Andrade, M.D.; Chata, G.; Peng, Y.; Roseman, G.; Lu, J.E.; Millhauser, G.L.; Saltikov, C.; Chen, S.W. Photo-enhanced antibacterial activity of ZnO/graphene quantum dot nanocomposites. Nanoscale 2018, 10, 158–166. [Google Scholar] [CrossRef] [PubMed]
- Liu, J.L.; Wang, Y.H.; Shen, J.H.; Liu, H.; Li, J.Q.; Wang, A.Q.; Hui, A.P.; AkifMunira, H. Superoxide anion: Critical source of high performance antibacterial activity in Co-Doped ZnO QDs. Ceram. Int. 2020, 46, 15822–15830. [Google Scholar] [CrossRef]
- Sivropoulou, A.; Papanikolaou, E.; Nikolaou, C.; Kokkini, S.; Lanaras, T.; Arsenakis, M. Antimicrobial and cytotoxic activities of origanum essential oils. J. Agric. Food Chem. 1996, 44, 1202–1205. [Google Scholar] [CrossRef]

| Concentrations of CAR (%) | SBET (m2/g) | Smicro (m2/g) | Sext (m2/g) | Vtotal (cm3/g) |
|---|---|---|---|---|
| 1 | 25 | − | 29 | 0.149 |
| 2.5 | 19 | − | 21 | 0.133 |
| 5 | 15 | − | 17 | 0.091 |
| 10 | 13 | − | 16 | 0.082 |
| 20 | 9 | − | 11 | 0.034 |
| PAL | 125 | 8 | 117 | 0.332 |
| ZnO/PAL | 27 | − | 33 | 0.158 |
Publisher’s Note: MDPI stays neutral with regard to jurisdictional claims in published maps and institutional affiliations. |
© 2021 by the authors. Licensee MDPI, Basel, Switzerland. This article is an open access article distributed under the terms and conditions of the Creative Commons Attribution (CC BY) license (https://creativecommons.org/licenses/by/4.0/).
Share and Cite
Hui, A.; Yang, F.; Yan, R.; Kang, Y.; Wang, A. Palygorskite-Based Organic–Inorganic Hybrid Nanocomposite for Enhanced Antibacterial Activities. Nanomaterials 2021, 11, 3230. https://doi.org/10.3390/nano11123230
Hui A, Yang F, Yan R, Kang Y, Wang A. Palygorskite-Based Organic–Inorganic Hybrid Nanocomposite for Enhanced Antibacterial Activities. Nanomaterials. 2021; 11(12):3230. https://doi.org/10.3390/nano11123230
Chicago/Turabian StyleHui, Aiping, Fangfang Yang, Rui Yan, Yuru Kang, and Aiqin Wang. 2021. "Palygorskite-Based Organic–Inorganic Hybrid Nanocomposite for Enhanced Antibacterial Activities" Nanomaterials 11, no. 12: 3230. https://doi.org/10.3390/nano11123230
APA StyleHui, A., Yang, F., Yan, R., Kang, Y., & Wang, A. (2021). Palygorskite-Based Organic–Inorganic Hybrid Nanocomposite for Enhanced Antibacterial Activities. Nanomaterials, 11(12), 3230. https://doi.org/10.3390/nano11123230

